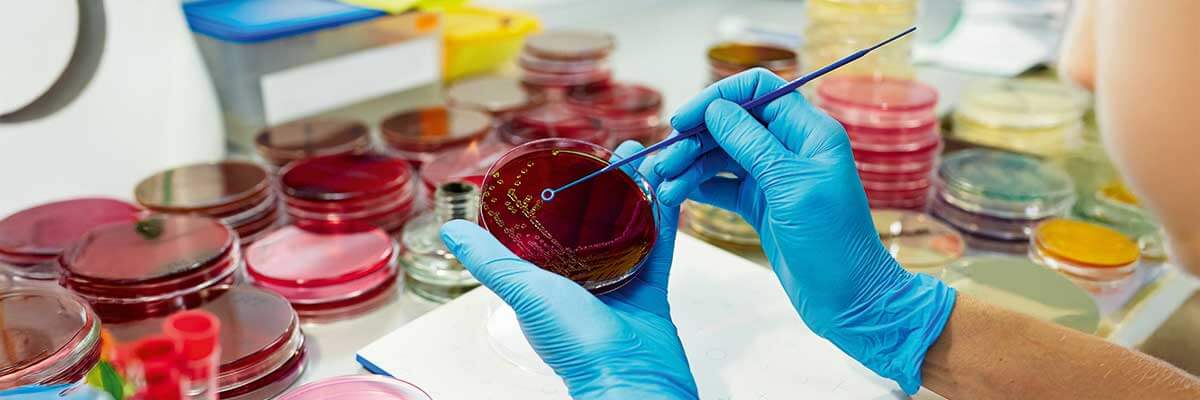
Mikrobiologe

Mikrobiologe
Ein Mikrobiologe ist ein Naturwissenschaftler, der sich mit der Erforschung von Mikroorganismen wie Bakterien, Viren, Pilzen und einzelligen Algen beschäftigt. Ziel seiner Arbeit ist es, die Eigenschaften, das Verhalten und die Wirkung dieser Organismen auf Mensch, Tier, Umwelt oder technische Prozesse zu verstehen und nutzbar zu machen. Mikrobiologen analysieren beispielsweise, wie Mikroben Krankheiten auslösen, Medikamente beeinflussen, biologische Kreisläufe steuern oder industrielle Verfahren unterstützen.
Sie arbeiten häufig in Forschungslaboren, Diagnostikzentren, der Pharmaindustrie oder in Umweltanalytik, wo sie mikrobiologische Proben untersuchen, neue Wirkstoffe identifizieren oder hygienische Standards überprüfen. Die Mikrobiologie ist ein Teilgebiet der Biologie und überschneidet sich mit Disziplinen wie Molekularbiologie, Biotechnologie, Medizin und Umweltwissenschaften.
Inhalt
Mikrobiologe Aufgaben
Ein Mikrobiologe untersucht Mikroorganismen wie Bakterien, Viren, Pilze oder Algen, um deren Eigenschaften, Lebensprozesse und Auswirkungen auf andere Organismen oder technische Systeme zu verstehen. Dabei arbeitet er häufig im Labor, entwickelt neue Nachweismethoden oder analysiert Proben aus Umwelt, Medizin oder Industrie.
Welche Aufgaben hat ein Mikrobiologe?
Je nach Fachrichtung und Branche kann der Arbeitsalltag unterschiedlich aussehen. Zu den typischen Aufgaben gehören:
- Untersuchung und Kultivierung von Mikroorganismen
- Entwicklung oder Anwendung mikrobiologischer Nachweismethoden
- Analyse von Proben aus Medizin, Umwelt, Lebensmitteln oder Industrieprozessen
- Dokumentation und Auswertung experimenteller Daten
- Entwicklung neuer mikrobiologischer Verfahren oder Produkte
Arbeiten im mikrobiologischen Labor
Im Labor züchten Mikrobiologen gezielt Mikroorganismen auf Nährmedien, um deren Wachstum, Stoffwechsel oder Reaktion auf Wirkstoffe zu analysieren. Dabei wenden sie Techniken wie Gram-Färbung, PCR, ELISA oder Mikroskopie an. Sie identifizieren krankmachende Keime, prüfen die Wirksamkeit von Antibiotika oder testen Proben auf Verunreinigungen. Die Einhaltung steriler Arbeitsbedingungen ist dabei ebenso zentral wie die präzise Dokumentation jeder Probe.
Datenanalyse und Auswertung
Die gewonnenen Ergebnisse werden statistisch ausgewertet, verglichen und grafisch aufbereitet. Mikrobiologen analysieren beispielsweise, wie sich Bakterien unter bestimmten Umweltbedingungen verhalten oder wie effizient ein neuer Wirkstoff gegen einen Erreger wirkt. Dazu nutzen sie Softwarelösungen für Bildauswertung, Gensequenzierung oder numerische Modellierung. Die Analyse dient als Grundlage für wissenschaftliche Publikationen, Berichte oder produktbezogene Entscheidungen.
Was ist das durchschnittliche Gehalt als Mikrobiologe?
brutto pro Jahr
Das Durchschnittsgehalt als Mikrobiologe beträgt 57.657 €. Die Gehaltsspanne in diesem Berufsfeld reicht von 49.069 € bis 64.920 € .
Wie viel ist das netto? Berechne es mit unserem Brutto-Netto-Rechner.
Entwicklung neuer Verfahren und Anwendungen
Ein weiterer Aufgabenbereich ist die Entwicklung neuer mikrobiologischer Methoden oder die Optimierung bestehender Prozesse. Mikrobiologen arbeiten an der Herstellung probiotischer Präparate, an biotechnologischen Produktionsverfahren oder an Schnelltests zur Diagnostik. Auch in der Umweltmikrobiologie entwickeln sie Verfahren zur biologischen Abwasserreinigung oder Schadstoffabbau. In interdisziplinären Teams bringen sie ihr Fachwissen in angewandte Forschung, Produktentwicklung oder Qualitätssicherung ein.
Wie wird man Mikrobiologe?
Um Mikrobiologe zu werden, ist in der Regel ein naturwissenschaftliches Studium im Bereich Biologie oder Mikrobiologie erforderlich. Der klassische Weg führt über ein Biologie-Bachelorstudium mit anschließender Spezialisierung im Masterstudium. Für viele Tätigkeiten in Forschung und Entwicklung ist zudem eine Promotion notwendig.
Studium und Spezialisierung
Der Einstieg erfolgt meist über ein Bachelorstudium in Biologie, das sechs Semester dauert. In den ersten Semestern erwerben Studierende Grundlagenwissen in Zellbiologie, Chemie, Physik, Mathematik und Statistik. Mikrobiologische Themen werden oft ab dem dritten Semester eingeführt.
Im Anschluss folgt ein Masterstudium, das in der Regel bier Semester umfasst. Hier erfolgt die gezielte Spezialisierung in Bereichen wie Mikrobiologie, Molekularbiologie, Infektionsbiologie oder Biotechnologie. Das Masterstudium ist forschungsorientiert, enthält vertiefte Laborpraktika und schließt mit einer wissenschaftlichen Masterarbeit ab.
Einige Hochschulen bieten mittlerweile auch konsekutive oder spezialisierte Mikrobiologie-Masterstudiengänge an, bei denen der Schwerpunkt von Beginn an auf mikrobiologischen Methoden, Anwendungen und Forschungsfragen liegt.
Promotion und Forschungskarriere
Wer in der akademischen Forschung, klinischen Diagnostik oder industriellen Produktentwicklung arbeiten möchte, absolviert nach dem Masterstudium in der Regel eine Promotion. Die Dauer liegt meist zwischen drei und fünf Jahren. Während dieser Zeit arbeiten Doktorandinnen und Doktoranden an einem eigenen Forschungsprojekt, sammeln Publikationserfahrung und nehmen an internationalen Konferenzen teil.
Voraussetzungen für Mikrobiologen
Mikrobiologen benötigen eine fundierte naturwissenschaftliche Ausbildung, ein ausgeprägtes Interesse an mikrobiellen Prozessen und die Fähigkeit, im Labor präzise und sorgfältig zu arbeiten. Neben fachlichem Wissen spielen auch persönliche Eigenschaften eine wichtige Rolle, da viele Tätigkeiten komplexe Analysen, langfristige Versuchsreihen und die enge Zusammenarbeit in Forschungsteams erfordern.
Fachliche Voraussetzungen
Grundlegend ist ein abgeschlossenes Studium der Biologie, Mikrobiologie oder eines verwandten Fachs. Bereits im Studium werden Kenntnisse in Zellbiologie, Biochemie, Molekularbiologie und Statistik vermittelt. Für die spätere Arbeit sind insbesondere folgende Fachkenntnisse relevant:
- Mikroskopiertechniken zur Beobachtung von Zellstrukturen und mikrobiellen Bewegungen
- Molekularbiologische Methoden wie PCR, DNA-Sequenzierung oder Klonierung
- Steriltechnik und Kultivierung von Mikroorganismen in Laborumgebungen
- Bioinformatik und Datenanalyse zur Auswertung genetischer oder mikrobiologischer Daten
- Kenntnisse in chemischer Analytik, z.B. HPLC oder Spektroskopie
Zusätzlich ist ein sicherer Umgang mit wissenschaftlicher Fachliteratur und englischsprachigen Publikationen unerlässlich, da Mikrobiologen international vernetzt sind.
Persönliche Eigenschaften
Mikrobiologen arbeiten oft über längere Zeiträume an komplexen Versuchsreihen oder Forschungsprojekten. Daher sind bestimmte persönliche Eigenschaften entscheidend für den beruflichen Erfolg:
- Sorgfalt und Genauigkeit, insbesondere bei der Probenvorbereitung und Auswertung
- Analytisches Denken, um Ergebnisse kritisch zu prüfen und komplexe Zusammenhänge zu erfassen
- Geduld und Ausdauer, da viele mikrobiologische Prozesse zeitaufwendig und wiederholungsintensiv sind
- Teamfähigkeit, da Forschung meist interdisziplinär und arbeitsteilig erfolgt
- Selbstorganisation, um Laborarbeit, Dokumentation und Auswertung effizient zu koordinieren
Spezialisierungen in der Mikrobiologie
Die Mikrobiologie ist ein vielseitiges Fachgebiet mit zahlreichen Spezialisierungsmöglichkeiten. Je nach Interessenslage und beruflicher Ausrichtung können Mikrobiologen in medizinischen, industriellen, ökologischen oder lebensmittelbezogenen Bereichen tätig sein. Jede Spezialisierung bringt eigene Methoden, Fragestellungen und Anwendungsfelder mit sich.
Medizinische Mikrobiologie
In der medizinischen Mikrobiologie stehen krankheitserregende Mikroorganismen im Fokus. Mikrobiologen in diesem Bereich identifizieren Bakterien, Viren, Pilze oder Parasiten in Patientenproben, bewerten deren Krankheitsrelevanz und prüfen die Empfindlichkeit gegenüber Antibiotika. Sie arbeiten eng mit klinischen Labors, Infektiologen und Hygienebeauftragten zusammen und tragen zur Diagnostik, Therapieüberwachung und Infektionsprävention bei.
Industrielle Mikrobiologie
In der industriellen Mikrobiologie werden Mikroorganismen gezielt für technische Prozesse genutzt. Mikrobiologen entwickeln und optimieren Fermentationsverfahren, bei denen Mikroben beispielsweise Enzyme, Vitamine, Biokunststoffe oder pharmazeutische Wirkstoffe produzieren. Auch in der Herstellung von Biotreibstoffen oder bei der biologischen Abfallverwertung spielen sie eine wichtige Rolle.
Mikrobiologe Lebenslauf

Umweltmikrobiologie
Die Umweltmikrobiologie untersucht die Rolle von Mikroorganismen in natürlichen und vom Menschen beeinflussten Ökosystemen. Mikrobiologen in diesem Bereich analysieren Boden- und Wasserproben, untersuchen mikrobielle Stoffkreisläufe und entwickeln Methoden zur biologischen Sanierung belasteter Standorte. Auch das Verhalten von Mikroben im Klimawandel oder deren Potenzial im CO₂-Abbau sind relevante Forschungsthemen.
Lebensmittelmikrobiologie
In dieser Spezialisierung befassen sich Mikrobiologen mit der mikrobiellen Sicherheit und Qualität von Lebensmitteln. Sie analysieren Rohstoffe, fertige Produkte und Produktionsumgebungen auf krankheitserregende Keime oder Verderbniserreger. Ziel ist es, hygienische Standards sicherzustellen und Risiken für Verbraucher zu minimieren. Auch die Entwicklung probiotischer Kulturen oder fermentierter Produkte zählt zu diesem Bereich.
Molekulare Mikrobiologie und mikrobielle Genetik
Mikrobiologen in diesem Bereich erforschen die genetischen Grundlagen mikrobieller Eigenschaften. Sie untersuchen Genregulation, Resistenzmechanismen, Stoffwechselwege oder Kommunikationsprozesse zwischen Zellen. Diese Spezialisierung ist besonders forschungsnah und findet Anwendung in der Entwicklung neuer Wirkstoffe, Impfstoffe oder gentechnisch veränderter Mikroorganismen.
Karrierechancen und Zukunftsaussichten für Mikrobiologen
Die Karrierechancen für Mikrobiologen sind insgesamt gut, insbesondere in Bereichen wie medizinischer Diagnostik, pharmazeutischer Forschung, Lebensmittelkontrolle und biotechnologischer Entwicklung. Die Nachfrage nach mikrobiologischem Fachwissen steigt kontinuierlich, vor allem durch globale Herausforderungen wie antibiotikaresistente Erreger, Pandemien, Klimawandel oder nachhaltige Produktionsprozesse.
Im akademischen Bereich ist die Konkurrenz um feste Stellen relativ hoch. Wer an einer Universität oder in einer öffentlichen Forschungseinrichtung arbeiten möchte, benötigt in der Regel eine Promotion und muss sich häufig über befristete Projektstellen profilieren. In der freien Wirtschaft dagegen bieten sich Mikrobiologen mit oder ohne Promotion vielfältige Einsatzmöglichkeiten, etwa in Laboren der pharmazeutischen Industrie, bei Herstellern biotechnologischer Produkte, in der Umweltanalytik oder in der Lebensmittelindustrie.
Wo gibt es aktuell die meisten Mikrobiologe Jobs?
Auch im öffentlichen Dienst, beispielsweise in Hygieneämtern, Umweltbehörden oder staatlichen Prüflaboren, werden regelmäßig mikrobiologisch ausgebildete Fachkräfte gesucht. Besonders gefragt sind Mikrobiologen mit Zusatzqualifikationen in Datenanalyse, Gentechnik oder Qualitätssicherung.
Die Zukunftsaussichten gelten als stabil bis wachsend. Durch den technologischen Fortschritt, die zunehmende Vernetzung biologischer und digitaler Daten sowie die wachsende Bedeutung biologischer Verfahren in Industrie und Medizin ergeben sich langfristig neue Aufgabenfelder. Mikrobiologen, die bereit sind, sich weiterzubilden und interdisziplinär zu arbeiten, haben sehr gute Chancen auf eine dauerhafte Beschäftigung mit Entwicklungspotenzial.
Was verdient ein Mikrobiologe?
Ein Mikrobiologe verdient in Deutschland durchschnittlich etwa 51.000 € brutto pro Jahr, was einem monatlichen Bruttogehalt von rund 4.250 € entspricht.
Das tatsächliche Einkommen variiert je nach Qualifikation, Branche, Region und Berufserfahrung. Berufseinsteiger mit einem abgeschlossenen Masterstudium verdienen in der Regel zwischen 42.000 € und 48.000 € brutto jährlich. In der Forschung an Universitäten oder öffentlichen Einrichtungen ist das Gehalt oft durch Tarifverträge geregelt, zum Beispiel nach dem Tarifvertrag der Länder (TV-L) in Entgeltgruppe E13, was etwa 4.400 € brutto pro Monat entspricht.
Mit einer abgeschlossenen Promotion verbessert sich die Gehaltsaussicht deutlich. Promovierte Mikrobiologen verdienen häufig zwischen 55.000 € und 70.000 € brutto jährlich, besonders wenn sie in der pharmazeutischen Industrie oder bei biotechnologischen Unternehmen arbeiten.
In der freien Wirtschaft sind die Gehälter oft höher als im öffentlichen Dienst. Mikrobiologen, die in leitenden Positionen arbeiten, zum Beispiel in der Qualitätssicherung, Produktentwicklung oder Projektleitung, können Jahresgehälter über 75.000 € erreichen.